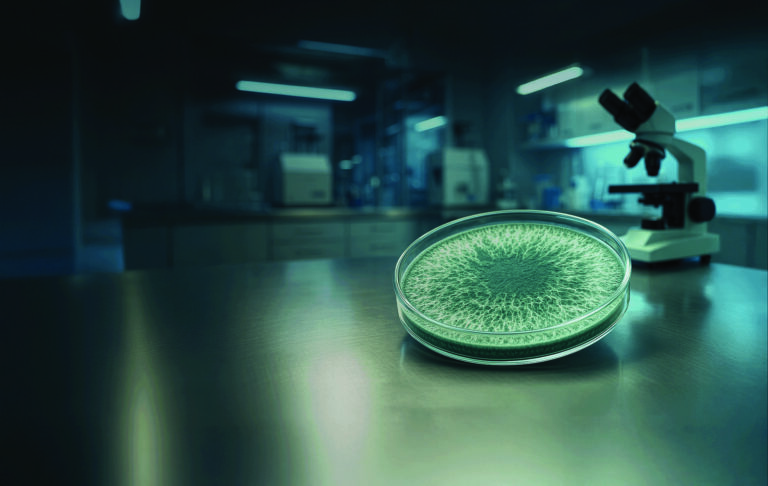
Trichodermil FS® é a nova aposta da Koppert para o tratamento industrial de sementes

O valor da terra também é cultivado
Quando o manejo do solo e do gado são sustentáveis, cada hectare destinado à pecuária passa a valer mais, seja qual for o tamanho da propriedade. Foi essa equação que garantiu a participação do Sítio São Gabriel II no terceiro episódio da websérie Top Sustainable Livestock